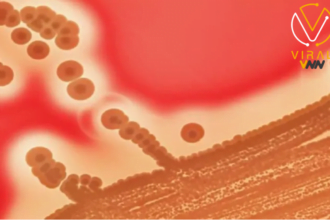
انتشار وباء مميت في اليابان

النتائج الأولية للتحقيقات الإسرائيلية حول غارة رفح
النتائج الأولية للتحقيقات الإسرائيلية حول غارة رفح النتائج الأولية للتحقيقات…
نداء رئيس الوزراء لتقديم دعم مالي للسلطة الفلسطينية
نداء رئيس الوزراء لتقديم دعم مالي للسلطة الفلسطينية نداء رئيس…
انتشار وباء مميت في اليابان
انتشار وباء مميت في اليابان انتشار وباء مميت في اليابان…
استمرار الصراع في الفاشر بين الجيش السوداني والدعم السريع
استمرار الصراع في الفاشر بين الجيش السوداني والدعم السريع استمرار…
تبادل لإطلاق النار بين القوات المصرية والاسرائيلية برفح
تبادل لإطلاق النار بين القوات المصرية والاسرائيلية برفح تبادل لإطلاق…
تطورات إيجابية لحالة رئيس وزراء سلوفاكيا بعد محاولة اغتياله
تطورات إيجابية لحالة رئيس وزراء سلوفاكيا بعد محاولة اغتياله تطورات…
سرقة صهريج مياه من قبل مستوطنين في منطقة الأغوار
سرقة صهريج مياه من قبل مستوطنين في منطقة الأغوار قام…
حزب الله يستهدف مبنى عسكريًا للاحتلال
حزب الله يستهدف مبنى عسكريًا للاحتلال حزب الله يستهدف مبنى…
إسبانيا والنرويج وأيرلندا تعلن اعترافها بالدولة الفلسطينية غداً
إسبانيا والنرويج وأيرلندا تعلن اعترافها بالدولة الفلسطينية غداً إسبانيا والنرويج…
شكوى جديدة ضد إسرائيل في المحكمة الجنائية الدولية
شكوى جديدة ضد إسرائيل في المحكمة الجنائية الدولية قدمت منظمة…